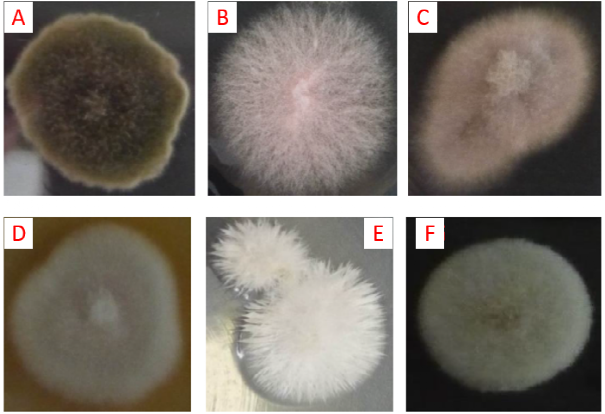

为进一步提高《微生物组实验手册》稿件质量,本项目新增大众评审环节。文章在通过同行评审后,采用公众号推送方式分享全文,任何人均可在线提交修改意见。公众号格式显示略有问题,建议电脑端点击文末阅读原文下载PDF审稿。在线文档(https://kdocs.cn/l/cL8RRqHIL)大众评审页面登记姓名、单位和行号索引的修改建议。修改意见的征集截止时间为推文发布后的72小时,文章将会结合有建设性的修改意见进一步修改后获得DOI在线发表,同时根据贡献程度列为审稿人或致谢。感谢广大同行提出宝贵意见。
为进一步提高《微生物组实验手册》稿件质量,本项目新增大众评审环节。文章在通过同行评审后,采用公众号推送方式分享全文,任何人均可在线提交修改意见。公众号格式显示略有问题,建议电脑端点击文末阅读原文下载PDF审稿。在线文档(https://kdocs.cn/l/cL8RRqHIL)大众评审页面登记姓名、单位和行号索引的修改建议。修改意见的征集截止时间为推文发布后的72小时,文章将会结合有建设性的修改意见进一步修改后获得DOI在线发表,同时根据贡献程度列为审稿人或致谢。感谢广大同行提出宝贵意见。
药用植物地下茎内生真菌的分离纯化及鉴定
Isolation, Purification and Identification of Endophytic Fungi in Chinese Mecicinal Plant Underground stem
祝英1 *, 巩晓芳1, 杨晖 1, 周剑平2, 王治业1
1甘肃省微生物资源开发利用重点实验室 甘肃省科学院生物研究所 甘肃 兰州
2甘肃省科学院自然能源研究所 甘肃 兰州
*通讯作者邮箱:zhuying_365@126.com
摘要:植物内生真菌不但能促进宿主植物生长,还能增强宿主植物抗旱、抗盐和抗病虫害的能力,特别是中药植物内生真菌能产生与中药植物相同或类似的生物活性物质,引起广大学者对中药植物内生真菌研究及功能开发的密切关注。内生真菌分离方法常采用组织表面消毒后破碎悬液培养法和去除表皮的组织块原位培养法。本文以药用植物桃儿七为例,利用改进原位组织块培养法不但能够分离得到内生真菌,还能清晰观察到内生真菌的着生部位,菌丝、孢子和菌落等生长状况,为药用植物地下茎内生真菌的分离、纯化、鉴定和功能开发提供可行、可靠的技术支撑。
关键词:中药植物,地下茎,内生真菌,组织块培养法
材料与试剂
1.无菌塑封取样袋(170 mm×120 mm、140 mm×100 mm)
2.花盆(220 mm×250 mm)
3.氯化汞消毒溶液
4. 纯净水(超纯水)
5.定性滤纸
6.75%乙醇溶液
7.葡萄糖(上海麦克林生化科技有限公司,麦克林,产品目录号:D810588)
8.琼脂(北京鼎国昌盛生物技术有限责任公司,VETEC, 产品目录号:V900500)
9.马铃薯(市场购买)
10.ITS通用引物订购(生工生物工程(上海)股份有限公司,合成部)
11.一次性培养皿
12. 真菌基因组DNA试剂盒(北京艾德莱科技生物有限公司,艾德莱,产品目录号:DN4102)
仪器设备
1.超净工作台(苏净集团苏州安泰空气技术有限公司,苏州安泰,型号:SW-CJ-1FD)
2.剪刀
3.手术刀
4.镊子
5.酒精灯
6.电炉
7.2L玻璃烧杯
8.霉菌培养箱(上海博讯实业有限公司医疗设备厂,型号:MJX-250B-Z)
9.立式压力蒸汽灭菌器(上海申安医疗机器厂,型号:LCZF-50KB-Ⅱ)
10.台式高速离心机(湖南赫西仪器装备有限公司,型号:TGL200MW)
11.电子精密天平(福州(美国)华志,型号:PTY223/323)
12.PCR扩增仪(Bio-Rad公司,Bio-Rad,型号:T100)
13.光学显微镜(Leica公司,Leica,型号:DM4-B)
软件和数据库
1.NCBI数据库BLAST(Basic Local Alignment Search Tool)(https://blast.ncbi.n66 lm.nih.gov/Blast.cgi)
2.BioEdit v7.2(https://bioedit.software.informer.com/7.2/)
3.GeneDoc v2.7.0(https://genedoc.software.informer.com/download/)
实验步骤
1.根系及根际土样品采集
以药用植物桃儿七地下茎内生真菌的分离、鉴定为例。实验样品为多年生桃儿七(Sinopodophyllum hexandrum)采自甘肃省兰州市榆中县兴隆山国家自然保护区,海拔2400 m。采样时间每年8月份左右,选择结果实的桃儿七植株,完整的将地下茎挖出,将根围泥土和根系一起放入取样袋中,带回实验室。以兴隆山桃儿七根围泥土为培养基质,将桃儿七地下茎栽种于实验室温室花盆内备用。
2.药用植物地下茎表面消毒
直接从温室栽培基质中挖取桃儿七地下茎,将地下茎用自来水冲洗干净,选取直径小于5 mm的地下茎按照下列程序表面消毒:75%酒精浸泡3-5 min,拿到无菌操作台用无菌水冲洗4次,用0.1%的升汞浸泡1-3 min,再用超纯水洗涤4次后,用灭菌滤纸吸干表面水分后,留做接种备用。
3.药用植物地下茎内生真菌分离
将上述处理好的桃儿七地下茎两端烧一下,用灭菌手术刀在放有灭菌滤纸的培养皿中切掉两端,再将中间茎段切成3 mm小片,分别种植到PDA培养基上,于25 ℃培养5 d,地下茎切口处长出内生真菌菌落 (图1B-F)。
为了验证表面消毒效果,将上述处理好的桃儿七地下茎切成小段,两端在酒精灯上烧一下后,种植在PDA培养基上为对照试验,于25 ℃培养5 d,地下茎切口处未长出内生真菌菌落 (图1A),表明表面消毒效果好。

图1 桃儿七地下茎内生真菌在PDA培养基上的生长情况 A:对照组;B-F:实验组
4.药用植物地下茎内生真菌纯化
将PDA培养基上药用植物地下茎段长出的菌丝分别挑去到PDA培养基上纯化,直到PDA培养基上长出单一菌落(见图2),一般纯化2-3次即可得到单一菌落。
图2 桃儿七地下茎内生真菌纯化单菌落菌株 A:Aspergillus ochraceus;B:Fusarium sp.;C:Beauvetia brongniaritii;D:未鉴定;E: Eucasphaeria capensis;F:未鉴定
5.药用植物地下茎内生真菌鉴定
5.1分子生物学鉴定 在无菌操作台上挑取纯化好的内生真菌菌丝,放置于1.5 ml无菌离心管中。用真菌基因组DNA试剂盒,按照说明书操作提取总DNA。以提取的总DNA为模板,用真菌检测鉴定通用引物ITS1和ITS4 (引物ITS1序列:5’-TCCGTAGGTGAACCTGCGG-3’;引物ITS4序列:5’-TCCTCCGCTTATTGATATGC-3’)进行PCR扩增。琼脂糖凝胶电泳检测到目的条带,送生工生物工程(上海)股份有限公司测序。得到测序结果利用BioEdit v7.2和GeneDoc v2.7.0软件经人工拼接后,在NCBI数据库中BLAST比对,对分离纯化的内生真菌菌株进行初步鉴定。
5.2 形态学鉴定 基于分子生物学鉴定结果,有目的的进行形态学鉴定,从桃儿七地下茎分离得到的4株内生真菌的分类地位、形态特征和基物见表1。
表1 4株桃儿七内生真菌的分类地位、形态特征和基物
分类群 Taxa | 分类地位 Taxonomic status | 形态特征 Morphological traits | 基物 Substrates |
赭曲霉(Aspergillus ochraceus) | Fungi; Dikarya; Ascomycota; Pezizomycotina; Eurotiomycetes; Eurotiomycetidae; Eurotiales; Aspergillaceae; Aspergillus. | 菌落在查氏琼脂培养基上25 ℃培养7 d直径25-35 mm,10-14 d 直径35-55 mm;质地丝绒状,分生孢子结构稠密,为暗黄褐色至赭色,老后不成黑色;菌丝体白色;产生菌核,但菌核较少,奶油黄色至紫褐色;分生孢子大多球形。 | 土壤,药材(枸杞子、玄参、杯牛滕、白芍),蘑菇、虫草,蚂蚁,羊粪,野果,霉腐物等 |
Eucasphaeria capensis | Fungi; Dikarya; Ascomycota; Pezizomycotina; Sordariomycetes; Hypocreomycetidae; Hypocreales; Hypocreales incertae sedis; Eucasphaeria; Eucasphaeria capensis | 菌落在PDA琼脂培养基上25 ℃培养7 d直径10-15 mm;子囊壳由子囊和假侧丝组成;子囊壳单生或簇生在子座上。子座和子囊壳柔软,有鲜明的淡黄色。 | 树皮、树叶、木材、植物根、高等真菌的老子实体和和土壤等 |
布氏白僵菌(Beauvetia brongniaritii) | Fungi; Dikarya; Ascomycota; Euascomycetidae; Xylariales; Clavicipitaceae; Cordyceps; Cordyceps brongniartii | 菌落在PDA培养基上培养5 d可长满平板,表面高低不同,菌丝初期为白色绒毛状或棉絮状,后期形成粉状,并呈现红色。分生孢子大多呈椭圆形,生于产孢细胞顶端开叉的“乙”形丝器上。 | 土壤、昆虫和植物根等 |
镰孢属(Fusarium sp.) | Fungi; Dikarya; Ascomycota; Pezizomycotina; Sordariomycetes; Hypocreomycetidae; Hypocreales; Nectriaceae; Fusarium | 菌落在PDA培养基上25 ℃培养7 d直径40-50 mm, 10 d可长满平板,菌丝初期为灰白色绒毛状,分生孢子座呈桂色;厚垣孢子圆形或卵圆形,壁光滑;分生孢子镰刀形;多芽型产孢细胞。 | 土壤和植物体等 |
结果与分析
在PDA培养基上培养5 d后观察,对照实验没有微生物生长,表明本实验消毒方法可靠。以地下茎表皮接触培养基的方式培养时(图1A、B和C),每个培养皿中接种6个根段,其中约3-6个地下茎段均有微生物菌落出现:多数是以丝状真菌和胶质状菌落共存,此情况的丝状真菌较难纯化。只有少数地下茎段出现单一菌落(图1B和C),但只要横切面一端长出丝状真菌菌落,另一端也有相同菌落生长(图1C)。以地下茎段横切面接触培养基的方式培养时(图1D、E和F),每个培养皿中接种10个根段,约6-8个根段均能见到丝状真菌生长,此培养方式胶质状菌落出现较少,多数以单菌落的形式在上横切面生长(图1F和G),在下横切面也有菌落生长(图1E)。由图1D、E和F实验结果可知,丝状真菌菌落多数从皮层组织长出,此结果与桃儿七地下茎真菌分布显微观察结果一致 (黄超杰 等,2008)。另外,实验结果还表明:从同一条地下茎分离到内生菌相似度较高;同一株不同地下茎内生菌的差异较大。
贾粟等 (2007) 采用桃儿七地下茎表面消毒后,用无菌刀片除去外部组织,再将内部组织切成0.5cm×0.5cm小片种植于PDA培养基上等方法来分内生菌。黄杰超等 (2008) 对桃儿七地下茎连续切片观察,发现较粗的地下茎菌丝分布几率较少,而且内生真菌仅存在于皮层细胞的一至二层处。本研究也曾尝试用此方法分离桃儿七地下茎内生真菌,但发现除去根外部组织的步骤不仅操作复杂、容易交叉污染的同时,还容易破坏皮层细胞,不易观察到内生真菌的着生位点和较纯的菌落。利用本研究提供的内生真菌分离方法,能可靠的分离纯化到根部内生真菌。该方法简单、易于操作。张昆等 (2008)、杨显志 (2003) 和李海燕 (1999; Debbab et al., 2009)等利用该方法成功的分离到多株桃儿七内生真菌,但他们没有提供内生菌分离的试验图片。药用植物内生真菌中有很多是不产孢的,首先通过诱导产孢法判断是否产孢,如果诱导产孢不成功,可利用多基因联合系统发育树进行进一步鉴定。本研究提供了内生菌的分离图片,能清晰看到内生真菌的着生部位,菌丝、孢子和菌落的生长情况,验证了该方法对植物根或地下茎内生真菌分离的可行性和可靠性。
大量的显微观察研究发现植物根部内生真菌菌丝的侵染部位主要集中在皮层细胞的某些区域,并不侵染内皮层和维管束 (谭小明等,2006;赵小锋等,2007)。图1D、E和F的研究结果从可培养微生物的角度进一步验证了内生真菌只集中在皮层细胞的某些区域。因此,在对植物根部内生真菌分离时,选择根的合适部位和可靠的分离方法是十分必要的。
对分离纯化的内生真菌先进行分子生物学鉴定,在分子生物学鉴定的基础上,再有目的地开展形态学观察和鉴定,核对真菌鉴定手册或真菌志上菌株的培养及形态特征,对分子生物学鉴定结果进行核对和验证,并可以在分子生物学鉴定结果的基础上进一步细分。例如在本研究中分子生物学方法对白僵菌菌株只鉴定到属,结合形态学分类将该菌株鉴定到种,为布氏白僵菌 (祝英等,2015)。目前真菌分类体系更新非常快,通常需要结合该属的最新分类学进展进行科学鉴定,一般通过mycobank就知道目前该属的描述物种的数量,通过相应的文献链接,可以清楚了解最新的物种检索表,以提高鉴定结果的可靠性。总之,先利用分子生物学鉴定再形态鉴定,不但能减少从海量资料中查找、搜索未知菌株形态特征的时间,而且还能对分子生物学鉴定结果进行核实、验证。该技术为药用植物地下茎内生真菌的分离、纯化和鉴定提供支撑,为药用植物地下茎内生真菌的功能开发和利用奠定基础。
溶液配方
1.马铃薯葡萄糖琼脂(PDA)培养基 (周德庆等,2006)
马铃薯200 g,葡萄糖20 g,琼脂15 g,自来水1000 ml,pH自然。
制备方法:马铃薯去皮后切成小块,加水煮沸20-30 min,用4层纱布过滤,滤液中加葡萄糖和琼脂,加热融化后再补充水分至1000 ml,121 ℃下灭菌20 min。
致谢
感谢国家科技部国际合作项目(2013DFA30950);甘肃省民生计划项目(1209FCMA003);甘肃省科学院创新团队项目(CX2019);甘肃省科学院应用研发项目(2018JK-15)和甘肃省科学院优秀青年基金项目(2016YQ-02&2019QN-02)对本研究的大力支持。
参考文献
1.黄超杰, 孟益聪, 冯虎元.(2008) 濒危药用植物桃儿七根的显微结构及其菌根真菌分布研究[J]. 菌物学报, 27(6): 922-929.
2.贾粟, 陈疏影, 翟永功, 等.(2007) 近年国内外植物内生菌产生物活性物质的研究进展[J]. 中草药, 38(11): 1750-1753.
3.张琨, 黄建新, 曹莉, 等. (2008) 桃儿七内生菌及产鬼臼类物质菌株的筛选[J]. 西北大学学报(自然科学版), 38(3): 431-434.
4.杨显志, 郭仕平. (2003) 鬼臼类植物产鬼臼毒素内生真菌的筛选[J]. 天然产物研究与开发, 15(5): 419-422.
5.李海燕, 王志军, 张玲琪, 等. (1999) 一种桃儿七内生真菌的分离初报[J]. 云南大学学报, 21(3): 47-48.
6.Debbab A, Aly AH, Edrada-Ebel R, et al. (2009) Bioactive metabolites from the endophytic fungus Stemphylium globuliferum isolated from Mentha pulegium[J]. Journal of Natural Products, 72(4): 626-631.
7.谭小明, 郭顺星, 周雅琴, 等. (2006) 七叶一枝花根的显微结构及其内生真菌分布研究[J]. 菌物学报, 25(2): 227-233.
8.赵小锋, 杨晖, 陈欣欣, 等. (2007) 桃儿七地下茎的显微结构及内生真菌分布[J]. 甘肃科学学报, 19(3): 86-87.
9.祝英, 王治业, 杨晖, 等. 桃儿七地下茎内生真菌的分离和鉴定[J]. 中国现代中药, 2015, 17(6): 572-576.
10.周德庆. 微生物学实验教程[M]. 高等教育出版社, 2006: 372.
猜你喜欢
10000+:菌群分析 宝宝与猫狗 梅毒狂想曲 提DNA发Nature Cell专刊 肠道指挥大脑
文献阅读 热心肠 SemanticScholar Geenmedical
16S功能预测 PICRUSt FAPROTAX Bugbase Tax4Fun
生物科普: 肠道细菌 人体上的生命 生命大跃进 细胞暗战 人体奥秘
写在后面
为鼓励读者交流、快速解决科研困难,我们建立了“宏基因组”专业讨论群,目前己有国内外5000+ 一线科研人员加入。参与讨论,获得专业解答,欢迎分享此文至朋友圈,并扫码加主编好友带你入群,务必备注“姓名-单位-研究方向-职称/年级”。PI请明示身份,另有海内外微生物相关PI群供大佬合作交流。技术问题寻求帮助,首先阅读《如何优雅的提问》学习解决问题思路,仍未解决群内讨论,问题不私聊,帮助同行。

学习16S扩增子、宏基因组科研思路和分析实战,关注“宏基因组”
 点击阅读原文下载PDF审稿,或浏览器直接访问下载链接:http://210.75.224.110/github/MicrobiomeProtocol/04Review/210429/2103957YingZhu980137/Protocol2103957.pdf
点击阅读原文下载PDF审稿,或浏览器直接访问下载链接:http://210.75.224.110/github/MicrobiomeProtocol/04Review/210429/2103957YingZhu980137/Protocol2103957.pdf























 1227
1227

 被折叠的 条评论
为什么被折叠?
被折叠的 条评论
为什么被折叠?








